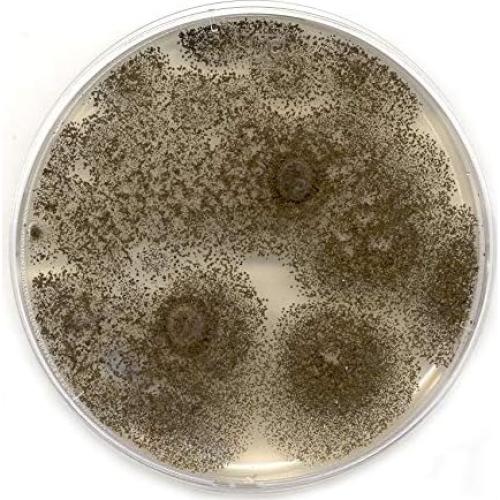
Placas de Agar de Extracto de Malta MEA EZ BioResearch - 10 Unidades
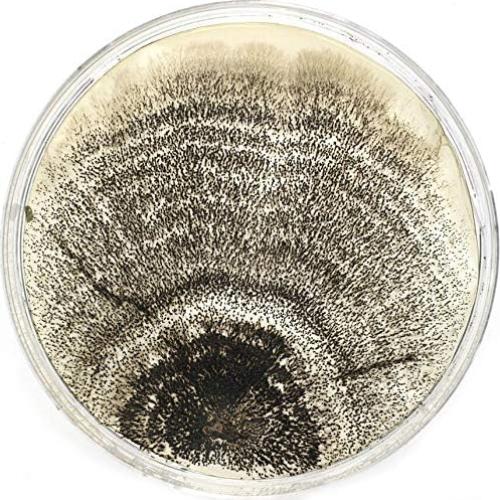
Placas de Agar de Extracto de Malta MEA EZ BioResearch - 10 Unidades

Best Naturals
Placas de Agar de Extracto de Malta MEA EZ BioResearch - 10 Unidades

300+ vendidos
Placas de Agar de Extracto de Malta MEA EZ BioResearch - 10 Unidades
$79.833
+ impuestos: $16.765
Llega a domicilio entre el 3 y el 8 de feb
- Compra protegida
- Envío a todo el país
- Garantía de entrega
Características destacadas
- Las Placas de Agar de Extracto de Malta Preparadas de EZ BioResearch son la opción preferida para el cultivo de hongos. Nuestras placas de agar MEA están hechas con extracto de malta premium real como ingrediente, lo que asegura su calidad superior para el crecimiento del micelio. Nuestro sistema de filtración activa a escala industrial también asegura que no haya residuos de malta en las placas de agar, a diferencia de las MEA ofrecidas por otros proveedores.
- Las Placas de Agar de Extracto de Malta Preparadas de EZ BioResearch pueden ser utilizadas para una variedad de usos, como la detección de moho y hongos y proyectos de ferias científicas. ¡Los estudiantes también pueden usar nuestras placas de agar porque son seguras! Este es un interesante kit de ciencia para aprender microbiología y para uso en laboratorio.
- Las Placas de Agar de Extracto de Malta Preparadas de EZ Bioresearch están preparadas con una capa gruesa de agar que es buena para el desarrollo de hongos. La superficie gruesa de agar previene el agrietamiento y secado de las placas. Las placas MEA preparadas son más fáciles de usar y mucho más eficientes que hacerlas por tu cuenta.
- Las Placas de Agar de Extracto de Malta Preparadas de EZ Bioresearch se fabrican en una instalación de manufactura industrial, por lo que puedes estar seguro de que la calidad de las placas MEA es consistente de lote a lote. Ofrecemos garantía de calidad del 100%. Si tienes algún problema con tu pedido, ofrecemos soporte al cliente gratuito con un número de teléfono gratuito.
Opiniones de compradores
856 opiniones
Eileen
Pensé que venían con parafilm, pero no hubo contaminaciones. Usé algunos y obtuve excelentes resultados. Quedan un par en el empaque original y no hay contaminaciones ni condensación.
The dude
Estos funcionaron genial. No hubo problemas de contaminación, pero una vez que los abres o los desen envuelves, ten mucho cuidado con la forma en que los almacenas hasta su uso. Como las tapas simplemente se colocan y no se enroscan hasta el fondo, al menos en mi caso, encontré fácil que se cayera la tapa si no tengo cuidado, así que lo que hago ahora es, después de abrir el paquete y quitar cuidadosamente solo los platos que planeo usar, luego envuelvo el empaque de nuevo sobre los platos no ut
Sean C.
Buen producto y bien envuelto. No sabía muy bien lo que estaba haciendo, pero le daré otra oportunidad.
JT$
Llegaron buenos platos a tiempo, justo para un buen uso y son una buena relación calidad-precio. Lo más importante es que estaban limpios.
Kim Vincent
Esperé unos meses antes de usar estos platos y los encontré contaminados con moho cuando los abrí. Estuvieron en un cajón aún envueltos en el plástico de burbujas y la bolsa de plástico. Lamentablemente, cuando finalmente abrí el paquete, 6 de 10 estaban contaminados con moho.
Descripción
Especificaciones técnicas
- Fabricante
- EZ BioResearch LLC
- Dimensiones del producto
- 12.7 x 12.7 x 20.3 centímetros; 425 gramos
- Está descontinuado por el fabricante
- No
Preguntas y respuestas
Tu pregunta fue enviada. Te responderemos pronto.
¿Dónde te enviamos la respuesta?
Tus preguntas
· Recibirás la respuesta a
Productos relacionados
Kneadace






